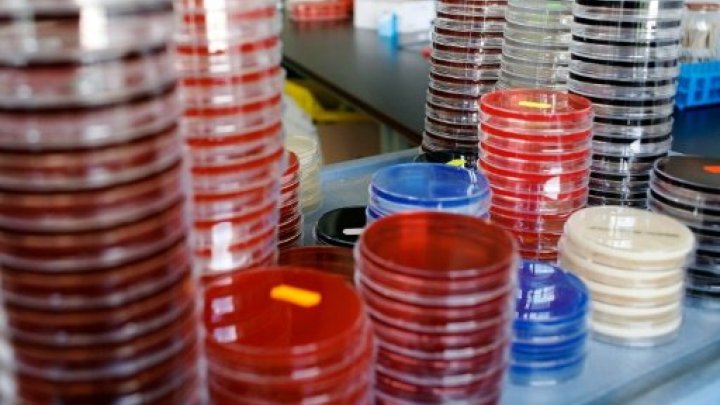

أ ف ب -تمكن أحد الفرنسيين من إنقاذ ساقه المهددة بالبتر، بفضل طريقة طواها النسيان منذ شيوع استخدام المضادات الحيوية، وهي الاعتماد على فيروسات تأكل البكتيريا.بعد 49 عملية جراحية والتهابات مقاومة للعلاجات لم تترك بدا من البتر، تمكن كريستوف من إنقاذ ساقه بفضل طريقة طواها النسيان منذ شيوع استخدام المضادات الحيوية، وهي الاعتماد على فيروسات تأكل البكتيريا.
وتوصل الفرنسي كريستوف نوفو البالغ 47 عاما إلى هذا الحل بفضل رحلة قام بها إلى جورجيا، أحد آخر بلدان العالم التي ما زالت تعتمد العلاج بالعاثية، أي استخدام الفيروسات لمهاجمة البكتيريا.ومنذ نحو 15 عاما، تلتفت الأنظار مجددا إلى هذا الأسلوب العلاجي القديم في بلدان مثل الولايات المتحدة وبلجيكا وفرنسا، وذلك فيما تبدي البكتيريات مقاومة متزايدة إزاء المضادات، وهو تحد يثير القلق على مستوى العالم.
في تشرين الثاني/نوفمبر الماضي، حذرت منظمة الصحة العالمية من أن بقاء الاستخدام المفرط والخاطئ للمضادات الحيوية على ما هو عليه، يمكن أن يجعل العالم في مرحلة "ما بعد المضادات الحيوية"، التي تعود فيها بعض الإصابات الشائعة والقابلة للعلاج حاليا، لتكون قاتلة.ويقول الطبيب آلان دوبلانشيه أحد رواد إعادة إحياء العلاج بالفيروسات أن هذه الطريقة "يمكن أن تستخدم في علاج الالتهابات في العظام والمفاصل، وأيضا في التهابات المسالك البولية والرئتين والعينين".
واكتشفت هذه الطريقة العلاجية أثناء الحرب العالمية الأولى، وتطورت بعد ذلك في العقدين الثاني والثالث من القرن العشرين، وهي تقوم على استخدام الفيروسات الآكلة للبكتيريا (العاثية) الموجودة بكثرة في الطبيعة وفي المياه المستخدمة وفي جسم الإنسان ولاسيما في الأمعاء.وهذه الفيروسات لديها تأثير أضيق نطاقا من المضادات الحيوية، فهي تدمر البكتيريات من دون أن تسبب أي أذى للجسم، بحسب دوبلانشيه الذي يؤكد أنه عالج نحو 15 مريضا بهذا الأسلوب في السنوات الماضية.ويستغرق العلاج عادة مدة قصيرة لا تزيد عن أسبوعين إلى ثلاثة، وهو أقل تكلفة من استخدام المضادات الحيوية.
- المختبرات غير مهتمة -
لكن تطور هذا العلاج تعرقله قلة اهتمام المختبرات به، لأن الفيروسات المستخدمة تستخرج من الطبيعة وهي بالتالي ليست تركيبات لديها براءات اختراع.ويقول جان كارليه المتخصص في علوم الأمراض المعدية والمستشار في منظمة الصحة العالمية "المختبرات تخلت عن الاهتمام بهذا المجال لأن عائداته المالية ضعيفة".
غير أن بعض الشركات الناشئة بدأت بالاهتمام بهذا العلاج الذي أقره الاتحاد الأوروبي في العام 2011، رغم أنه ما من فيروس محدد أقر استخدامه على البشر، وذلك بسبب الحاجة إلى إجراء تجارب سريرية "قد تستغرق سنوات عدة وتكلف الكثير من المال" بحسب الطبيب جان بول بيرناي العامل في مستشفى الملكة استريد في بروكسل، أحد المستشفيات القليلة التي تعتمد هذا العلاج خارج دول الاتحاد السوفياتي السابق.
في الولايات المتحدة، أقر استخدام بعض الفيروسات المهاجمة للبكتيريا، ولكن فقط في مجال السلامة الغذائية، وليس في مجال الطب.وفي العام 2013، أطلق الاتحاد الأوروبي مشروعا أول في هذا المجال تحت اسم "فاغوبورن"، لاختبار الفيروسات الفعالة في القضاء على البكتيريات المقاومة للمضادات والتي تهاجم القروح الناجمة عن الحروق، بمشاركة 12 مصابا من فرنسا وبلجيكا وسويسرا.
وقبل انتظار النتائج، أعطت الوكالة الفرنسية للأدوية موافقتها الأولى لاستخدام العلاج على مصاب بحرق قوي في تشرين الثاني/نوفمبر الماضي.ولا يرى جان كارليه أن هذه الطريقة العلاجية ستطيح تماما بالمضادات الحيوية، بل أنهما سيتكاملان، مشيرا أيضا إلى ضرورة الانتباه إلى الأثر الذي قد يسببه الاستخدام الواسع لهذه الفيروسات المضادة للبكتيريا على البيئة.